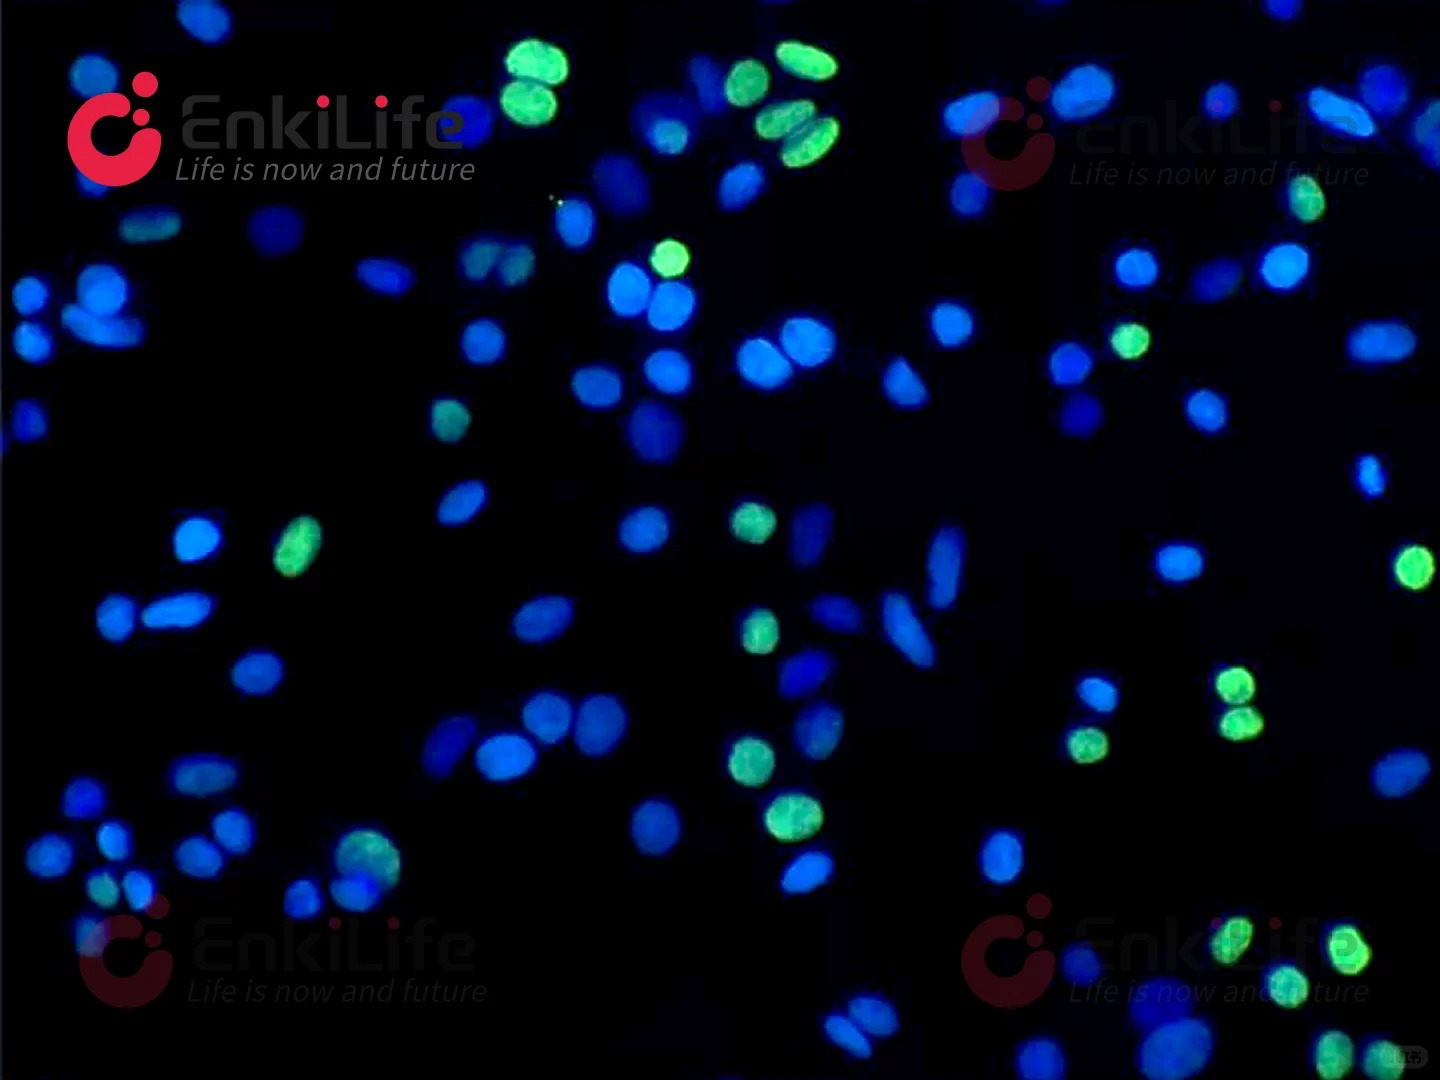

公司动态
TUNEL 细胞凋亡|点亮细胞的“谢幕瞬间”
发表时间:2025-10-14
? TUNEL的魔法原理 当细胞凋亡时,DNA会断裂成180-200bp的片段,暴露出大量“缺口”。TUNEL利用末端转移酶(TdT)给这些缺口打上荧光标签,就像在犯罪现场用荧光粉显影指纹,凋亡细胞在显微镜下瞬间亮起!

?? 实验室的私藏色号清单!TUNEL 5色荧光盘,一键调出「凋亡氛围感」?
?? Fluorescein 488 经典「薄荷绿」,亮度爆表,适合跟 DAPI 做「冷白皮」CP,新手零翻车。
?? Fluorescein 555 暖调「落日金」,专门配红色 mCherry,一张图凑齐「番茄炒蛋」,审稿人看着都饿了。
?? Fluorescein 594 复古「玫瑰红」,自带电影滤镜,拍肿瘤切片像拍王家卫电影,故事感拉满。
?? Fluorescein 640 高冷「绛紫」,远红光通道专属,背景干净到像给细胞开了磨皮。
?? 生物素标记 「无荧光」隐形墨水!想用 SA-HRP 做 DAB 显色 or 放大信号?它=万能打底色!
?? 实验小贴士:
阳性对照:用DNase I制造“人工凋亡”,验证体系有效性;
阴性对照:去掉TdT酶,排除非特异性染色;
避光!避光!避光!(重要的事说三遍)荧光淬灭比emo来得更快。
??细胞凋亡不是终点,而是生命精密调控的起点。
??用TUNEL,做生命终结的“第一目击者”!
上一篇:细胞增殖|目睹DNA“搬砖”全过程
下一篇:无